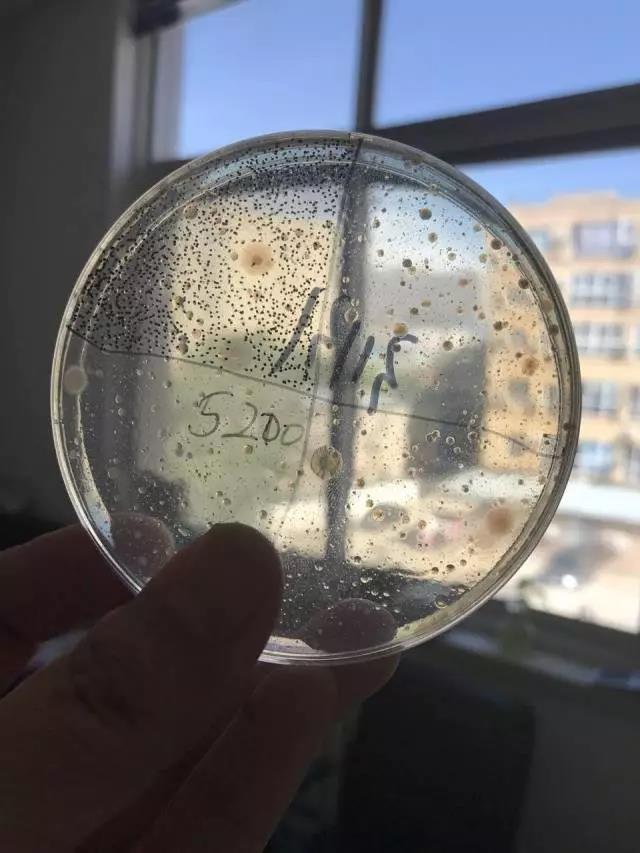

兑换所需积分:22770门店价¥99.00
重要提示:食品级的洗涤粉!
商品风格:400g
剩余数量:99份
兑换数量:1份
可用积分: 请登入
购买价格:¥99.00元积分¥22770
重要提示:食品级的洗涤粉!
商品风格:400g
剩余数量:99份
功效:祛除油污、杀菌去臭、5秒祛农药残留、持续15天抑菌驱虫。
特点:多功能,全天然,更环保,源自深海天然纯粹海洋生物因子及海藻类成分无磷弱碱性配方,无荧光剂、不含甲醛王基酚,安全无毒可以喝,洗衣、洗水果蔬菜、洗锅碗瓢盆、刷厕所马桶、拖地板等都可以使用。
Hi,你以为马桶冲一下水,看得见的污垢是没了,但它真的就干净了吗?
据外媒报道,冲水后立刻测量马桶内壁,细菌数量都达到了10万个。而马桶圈和马桶蹲座外侧的细菌数量更是内壁的几倍之多。
这样的马桶,你还坐得下去吗?
细菌病毒看不见也冲不走,还危害身体健康,很容易导致腹泻、过敏等症状。
更别提马桶还常常发出难闻的味道,除了默默忍受,难道就没有其他办法了吗?

针对当前生活中马桶普遍细菌超标的问题,友肌推出了一款杀菌率高达99.99%的多功能浓缩洗涤粉。

将洗涤粉倒入马桶中浸泡15-20分钟不仅能持续15天长效杀菌,还能有效除去马桶异味。
而且不仅仅是马桶,它还能给绝大部分物品杀菌。可以说是非常万能的杀菌洗涤粉了。
除了清洗衣物、卫浴设备、厨房、餐具、蔬果、地板等基础的家具清洁之外,友肌多功能浓缩洗涤粉能够针对特别顽固的污渍完成彻底的清洁作用,包括我们的爱车哦!
自从洗涤粉试用装发到代理们的手上,一个个都成了勤快的人,用代理的话说:不是我们不勤快,是没有遇到好的帮手。
让我们一起来见证这些姐妹的“成果”吧!



**首饰

小贴士:
机洗衣物:少量衣物(水位30公升)一匙友肌全效洗涤粉,大量衣物(水位60公升)二匙友肌全效洗涤粉,以温水搅匀后放入衣物浸泡30分钟以上。
手洗衣物:以平常洗衣粉计量,先用温水撑匀浸泡30分钟以上再洗效果更佳。
除了衣服上的脏污,门窗、鞋子、首饰的脏污你看到了吗?
**鞋子

一、清洗衣物
黄污也不见了






二、锅碗瓢盆
锅锅出场~~~~
洗污渍







三、油烟机
好了,你觉得这些小样,洗不掉丢了就算了,但油烟机呢?是说丢就丢的吗?








